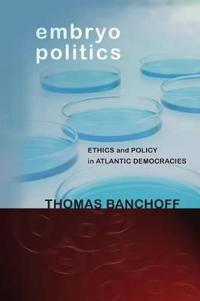

Religion and the Global Politics of Human Rights (Pocket)
avThomas Banchoff, Robert Wuthnow, Thomas Banchoff
ISBN: 9780195343380 - UTGIVEN: 201105Are human rights universal or the product of specific cultures? Is democracy a necessary condition for the achievement of human rights in practice? And when, if ever, is it legitimate for external actors to impose their understandings of human rights upon particular countries? In the contemporary co[...]
Embryo Politics (Pocket)
avThomas Banchoff
ISBN: 9780801478819 - UTGIVEN: 2013-06Since the first fertilization of a human egg in the laboratory in 1968, scientific and technological breakthroughs have raised ethical dilemmas and generated policy controversies on both sides of the Atlantic. Embryo, stem cell, and cloning research have provoked impassioned political debate about t[...]